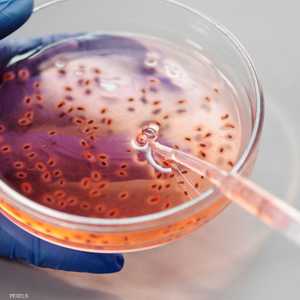
أرشيفية.. انتشار بكتيريا المكورات العنقودية "أي"

دراسة تكشف ضرر المضادات الحيوية على المدى الطويل
10:28 - 10 يناير 2023
حذرت دراسة حديثة الأشخاص الذين تزيد أعمارهم عن 40 عاما، ويتناولون المضادات الحيوية بانتظام، من أنهم أكثر عرضة للإصابة بالتهاب الأمعاء.
وقال باحثون من جامعة "نيويورك لانغون هيلث"، إن الخطر يبدو تراكميا، ويصل إلى أعلى نقطة له بعد عام إلى عامين من تناول المضادات الحيوية.
ويعاني قرابة 7 ملايين شخص في جميع أنحاء العالم من التهاب الأمعاء، ويتوقع مؤلفو الدراسة أن يرتفع هذا الرقم خلال العقد المقبل.
وربطت الدراسة بين ارتفاع احتمال إصابة الأشخاص الأصغر سنا (أقل من 40 عاما) بداء "كرون" والتهاب القولون التقرحي، باستخدام المضادات الحيوية.
وشملت الدراسة بيانات أكثر من 6 ملايين شخص (أكثر من نصفهم بقليل من الإناث)، تلقى 91 بالمئة منهم مضادا حيويا واحدا على الأقل بين عامي 2000 و2018.
وخلال فترة الدراسة، شخّص الأطباء أكثر من 36000 حالة جديدة من التهاب القولون التقرحي، وأكثر من 16800 حالة جديدة من مرض "كرون".
وبالمقارنة مع عدم استخدام المضادات الحيوية، وجدت الدراسة أن استخدام هذه الأدوية أظهر ارتباطا واضحا بخطر الإصابة بالتهاب الأمعاء، بغض النظر عن العمر، رغم كون المرضى الأكبر سنا هم الأكثر عرضة للخطر.
وأشار المؤلف الرئيسي للدراسة التي نشرت في مجلة "Gut" الطبية آدم فاي إلى أن أعلى مخاطر للإصابة بالتهاب الأمعاء كان بعد تناول المضادات الحيوية لفترة تراوحت بين 12 إلى عامين.
وقال فاي معلقا على الدراسة: "تستهدف المضادات الحيوية واسعة الطيف بشكل عشوائي جميع الميكروبات في الأمعاء، وليس فقط تلك التي تسبب المرض".
ودعا الباحثون إلى إجراء المزيد من التجارب، وذلك لاعتماد دراستهم على عنصر الملاحظة فقط، دون تحديد السبب النهائي الدقيق.
البستنة العلاجية.. فوائد ومآرب